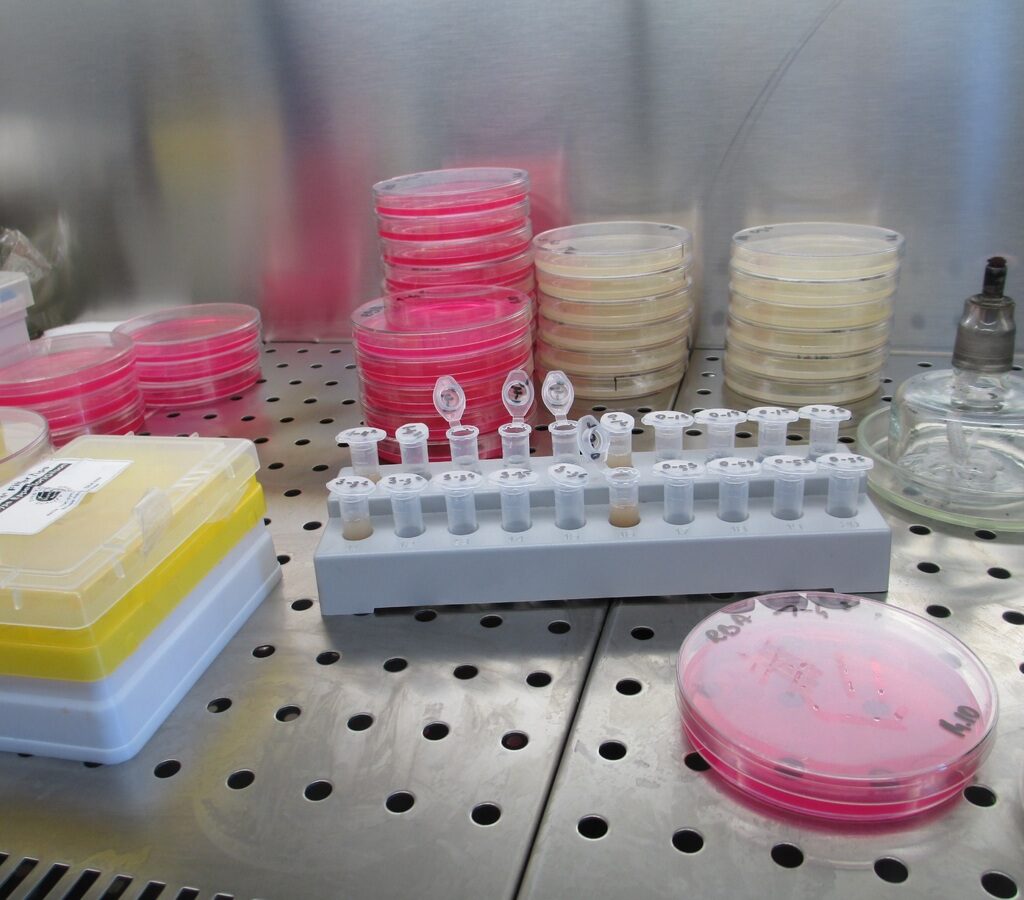

Foram reveladas as nove finalistas do Prémio Europeu para Mulheres Inovadoras 2026, uma iniciativa promovida pelo Instituto Europeu de Inovação e Tecnologia, em parceria com o Conselho Europeu de Inovação e a Agência Executiva do Conselho Europeu de Inovação e das PME. A distinção reconhece mulheres que estão a impulsionar a inovação na Europa, promovendo simultaneamente a igualdade de género e a diversidade no setor tecnológico e científico.
As finalistas estão distribuídas por três categorias: “Rising Innovators”, destinada a jovens com menos de 35 anos; “Women Innovators”, que distingue fundadoras e cofundadoras de empresas; e “EIT Women Leadership”, focada em líderes da comunidade EIT. As vencedoras serão anunciadas em junho, durante a EIC Summit 2026.
Na categoria de jovens inovadoras, destacam-se projetos que vão desde testes inovadores para deteção precoce do cancro da mama até soluções para a indústria farmacêutica e tecnologia espacial. Já na categoria principal, as finalistas apresentam avanços em áreas como saúde mental digital, inteligência artificial aplicada à medicina e cosmética sustentável com menor impacto ambiental.
Entre as finalistas, há também forte presença portuguesa na categoria de liderança, com Ella Cullen e Neide Vieira a integrarem a lista. As suas iniciativas destacam-se pelo uso de tecnologias como blockchain, inteligência artificial e biossensores para melhorar a rastreabilidade de produtos e acelerar diagnósticos médicos.
Criado há mais de uma década, o prémio tornou-se uma referência europeia na valorização do papel das mulheres na inovação. Ao reconhecer projetos com impacto social e ambiental, a iniciativa reforça a importância de uma liderança inclusiva para o desenvolvimento sustentável e a competitividade da União Europeia.